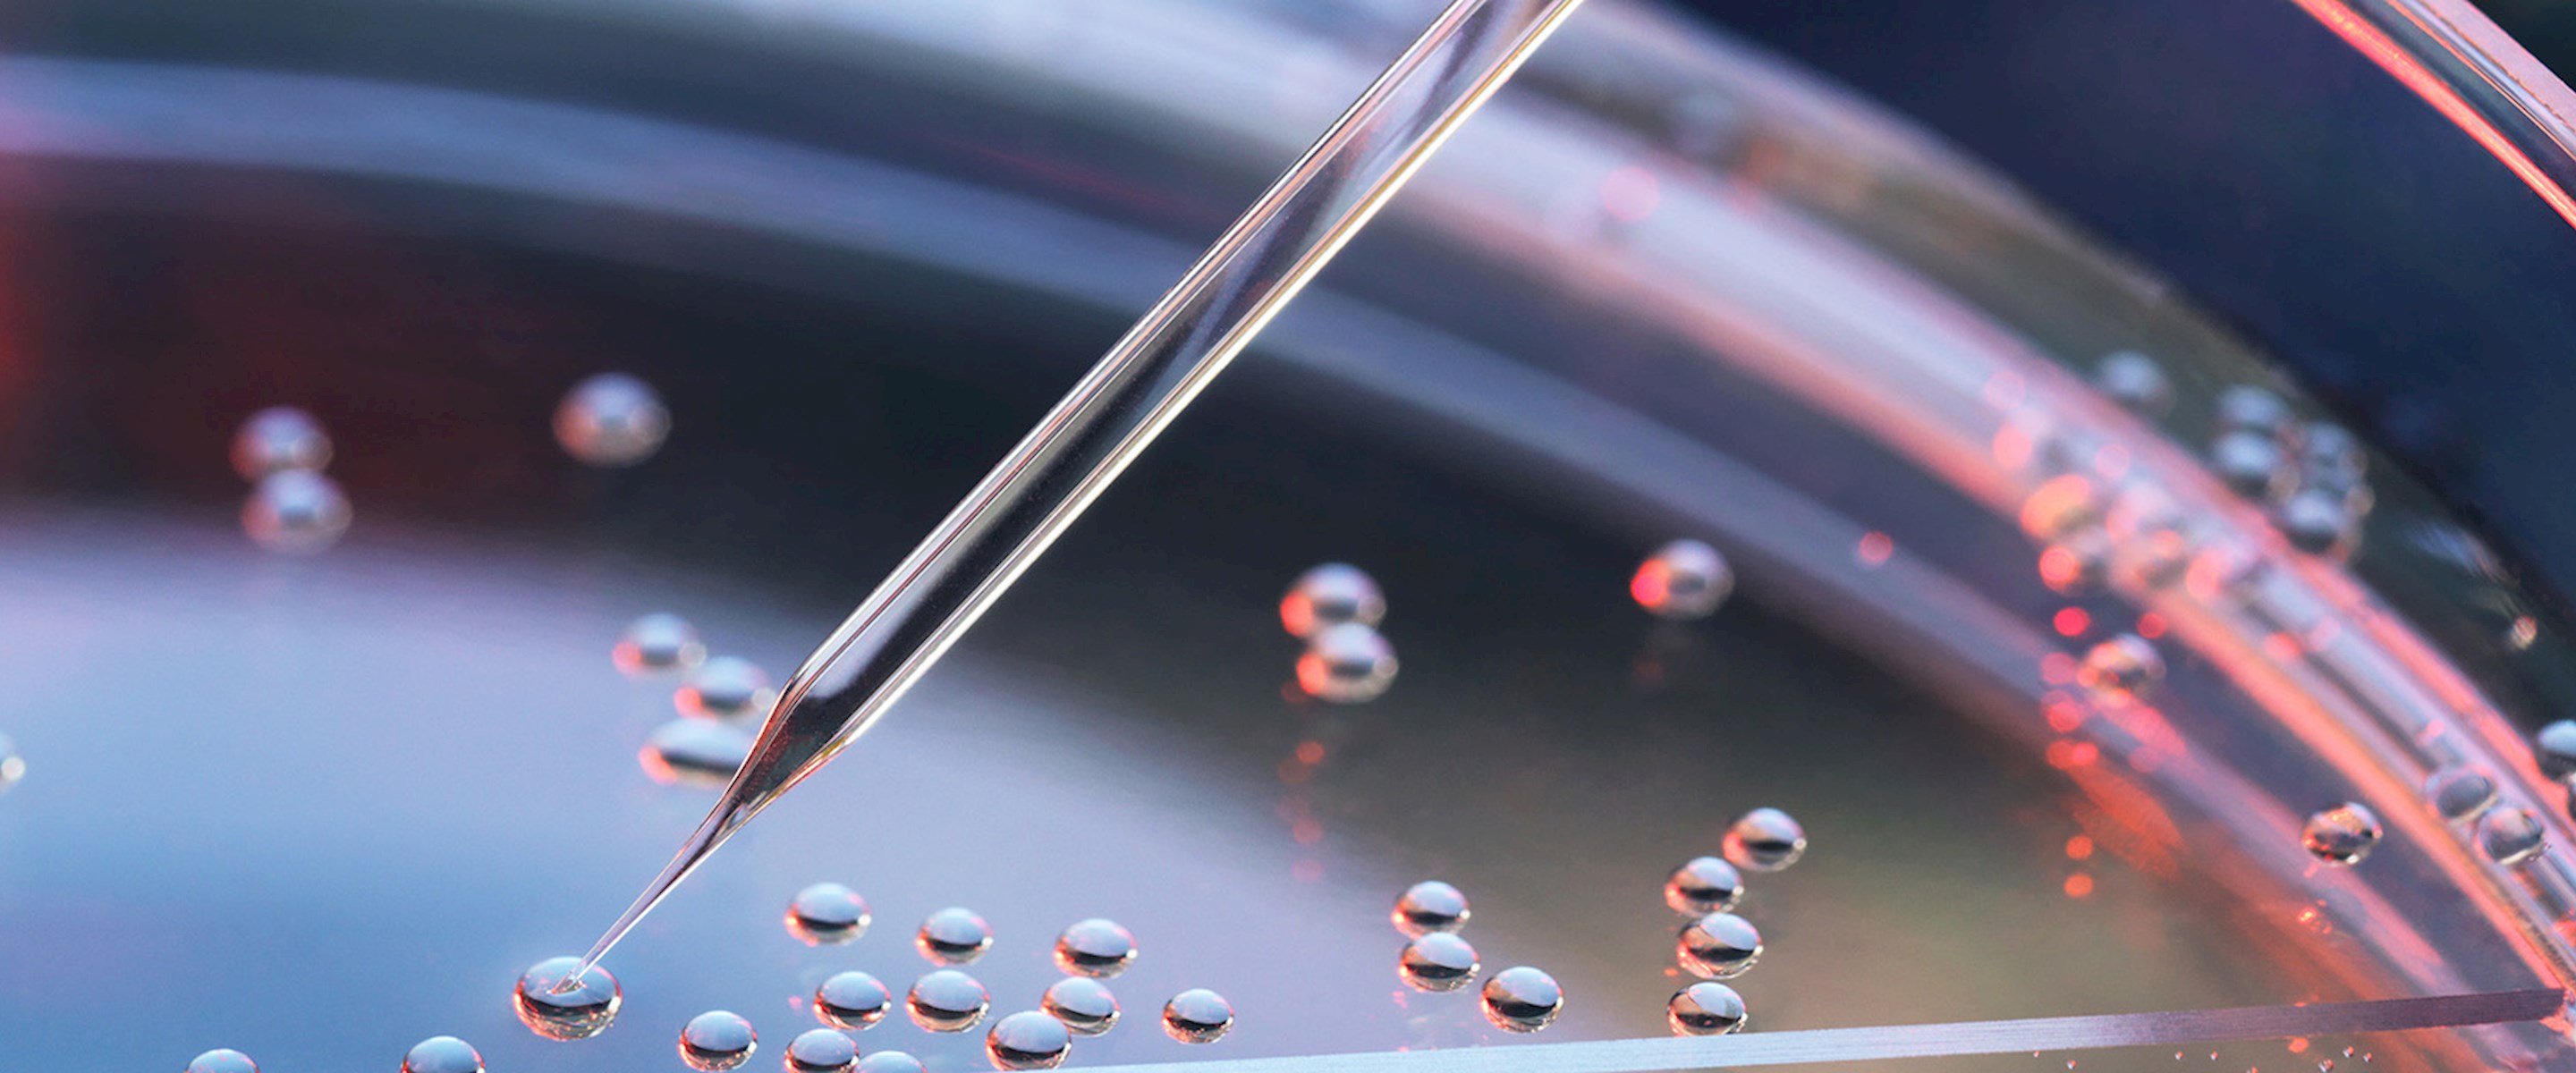
Petri dish closeup

Given the spread of COVID-19 and the mounting questions about what it means to society, our featured story in this issue of Client Focus is a conversation with Tim Lugo. He leads William Blair's biotech equity research team, which is at the center of what COVID-19 means from a health and investment perspective.
- Which companies are ramping up or retooling to meet the immediate needs from the spread of COVID-19?
- From the testing side Roche and Thermo Fisher are bringing new high-throughput technologies to the market right now, which should open up our capacity for testing exponentially over the next few weeks. Our diagnostics analysts Brian Weinstein and Matt Larew have been following these testing issues very closely and I suggest everyone read William Blair's research product Backstreets. It is published every Saturday and digs into the diagnostics and testing side of the U.S. healthcare system.
- What companies are on the frontline of developing a COVID-19 vaccine?
- A relatively small biotech Moderna has dosed its first patients with its mRNA-based vaccine the week of March 16. This is a relatively modern approach to vaccine development that leverages the known genetic sequence of SARS-CoV-2, the name for the virus which is now referred to as the cause of COVID-19. The short amount of time a company has been able to move from genetic sequence to the dosing of the first patient cannot be overemphasized. It's remarkable. We only had the first patients present to Chinese hospitals with COVID-19 in late December followed by the first U.S. patient in late January. And now we have a promising vaccine candidate. Johnson & Johnson has also nominated a candidate in partnership with the U.S. Department of Health & Human Services which will enter human testing in September.
I also expect a number of other promising candidates from academic centers and the traditional vaccine developers such as GlaxoSmithKline, Sanofi, and Merck to enter their own candidates into the clinic as there is a clear need for multiple candidates in case one of the candidates doesn't look as promising as originally thought. Vaccine development is like all drug development. Every theory needs to be tested and we can't broadly dose people until a candidate is proven safe and effective. However, it sounds like the regulators are fast tracking development of vaccines and antivirals and hopefully even the aggressive estimates of 1-1.5 years can be reached if not exceeded. Antivirals and other therapies that treat the negative effects of COVID-19 are likely to read out data prior to vaccines as measurements of viral reduction occur relatively rapidly and several large trials are already underway. The World Health Organization (WHO) lists over 500 trials currently related to COVID-19. So the effort to combat this disease is broad and significant worldwide.

- William Blair has always taken a long-term investment view. With that in mind, how are you thinking about a post-coronavirus environment?
- The disruption may be only several months or maybe a year and a half until we see the first vaccines. Taking a longer-term approach is definitely where investor minds should be as all pandemics ultimately pass through the population and end, sometimes after effective public health measures and a relatively measured impact and sometimes with grave consequences and loss of life. I think the rapid response of the biotech industry will lead to a changed perception of the industry, which for the past years had been a lightning rod for drug pricing despite the obvious innovation behind those drug prices.
- How could the spread of COVID-19 affect clinical trials, new drug launches, and FDA timelines? What are you watching?
- We've already seen disruptions to the healthcare system in select hotspots here in the United States and Europe and with those disruptions come clinical trial disruptions. Developers are trying to ship therapies directly to patients instead of requiring hospital visits and we see developers broadly moving toward online patient interactions. This is similar to companies currently launching new medicines. With any disruptions in patient-to-caregiver meetings we also expect the prescribing of new therapies to be negatively impacted. Hopefully for all of us these interruptions are short-lived.
- How do you see private/public sectors planning for the next epidemic?
- For many structural issues we have under invested in vaccines, antivirals, and next-generation antibiotics. I believe that is set to change dramatically as a result of the ongoing COVID-19 pandemic. Other themes likely to emerge will be the continued utilization of online meeting tools both within healthcare and by most industries. I also expect more scrutiny to supply chains and manufacturing in the future.
- What will you be watching most closely as COVID-19 spreads?
- As I touched on earlier, timelines are important. We'll also be watching new infection rates here in the United States like hawks. We're hopeful to have a leveling off of new infections after a rough few weeks as our testing capacity catches up to the currently undiagnosed cases. So expect some scary headlines in the next few weeks. However, I believe in our industry and the role it will have in bringing new therapies to the market which will help us through these anxious times.
To receive the firm's research reports, contact your William Blair representative. Visit williamblair.com/ResearchCoverage for disclosure information.